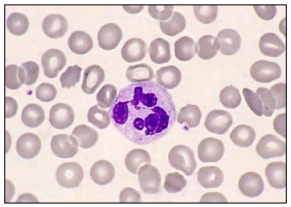
enunciado 668122-1

Foram encontradas 355 questões.
Ao realizar um exame parasitológico de fezes, o técnico em laboratório se depara com o seguinte ovo:

Este ovo corresponde a qual parasito?
Provas
Questão presente nas seguintes provas
Ao realizar uma hemoscopia, a seguinte célula imunológica aparece no campo:
É correto afirmar que essa célula é um:
Provas
Questão presente nas seguintes provas
De acordo com a Resolução nº 311 do Conselho Federal de Farmácia, o técnico em laboratório seguindo a ética
profissional pode exercer as seguintes funções, EXCETO:
Provas
Questão presente nas seguintes provas
A sífilis é uma doença sexualmente transmissível provocada pela bactérias Treponema pallidum. O primeiro sintoma
é uma ferida indolor no pênis, no ânus e vulva. O teste rápido laboratorial para detecção de sífilis é:
Provas
Questão presente nas seguintes provas
O Elisa é uma técnica de Imunoensaio Enzimático (EIA) heterogêneo, muito utilizada para diagnóstico, principalmente
por causa de seu baixo custo e por detectar quantidades extremamente pequenas de antígenos ou anticorpos. Esse
exame se baseia na detecção de anticorpos ou de antígenos específicos, através da reação anticorpo-antígeno. São
cromógenos utilizados para o teste Elisa, EXCETO:
Provas
Questão presente nas seguintes provas
A peça de laboratório cuja função é aquecer substâncias a seco e com grande intensidade, podendo ser levada ao bico
de Bunsen é:
Provas
Questão presente nas seguintes provas
Sobre a coloração de GRAM, a sequência de fases correta para a técnica é:
Provas
Questão presente nas seguintes provas
- Automação em Bibliotecas
- Gestão de Bibliotecas e Unidades de Informação
- Administração de Bibliotecas
- Automação de BibliotecasPreservação de Documentos Eletrônicos
- Organização e administração de bibliotecasAvaliação de bibliotecasPlanejamento de Bibliotecas
“A biblioteca de determinada instituição de ensino superior detalhou, em seu plano semestral, os procedimentos a
serem executados visando a preservação do acervo digital.” É correto afirmar que esse plano é produto do
planejamento
Provas
Questão presente nas seguintes provas
- Gestão de Bibliotecas e Unidades de Informação
- Gestão de Serviços de Informação
- Recursos e serviços de informaçãoServiço de Referência
Entre os serviços que uma biblioteca universitária oferece para a comunidade acadêmica, assinale aquele que NÃO é
concernente à referência.
Provas
Questão presente nas seguintes provas
“A seção de seleção tem, entre outras, a atribuição de organizar e manter atualizado o arquivo de catálogos de
editores e livreiros e outras informações referentes ao material documental, de sorte a poder recomendar aquisição
de interesse para a biblioteca.” É correto afirmar que essa atribuição é relativa a
Provas
Questão presente nas seguintes provas
Cadernos
Caderno Container